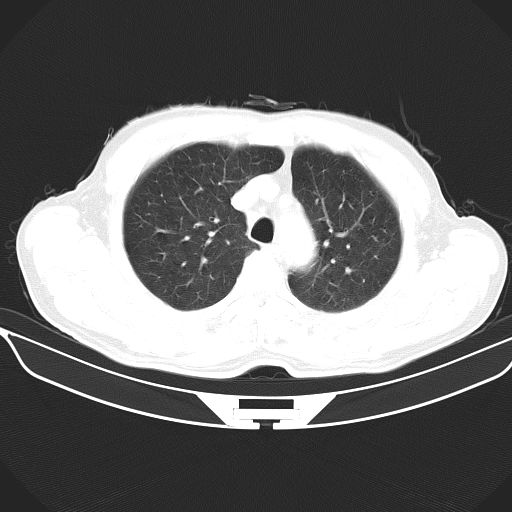
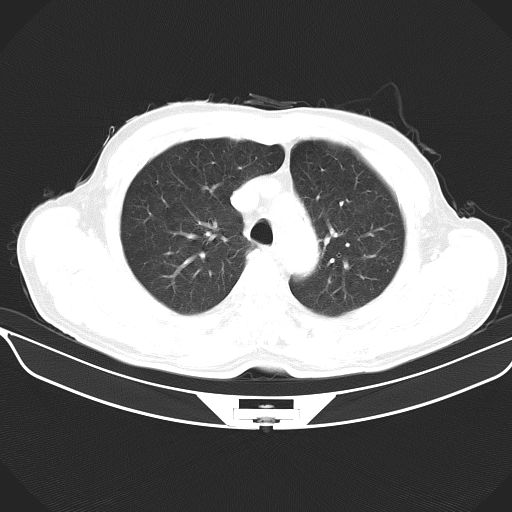
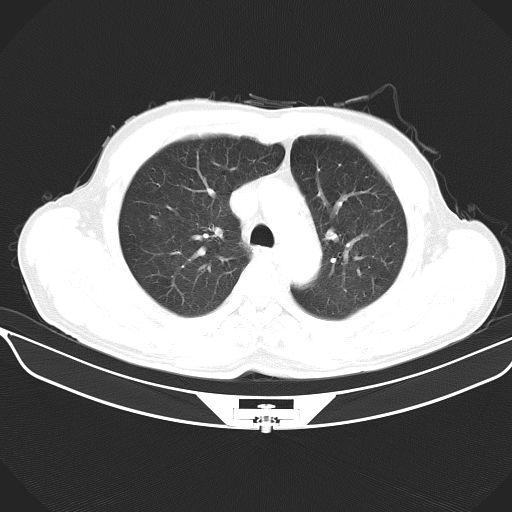
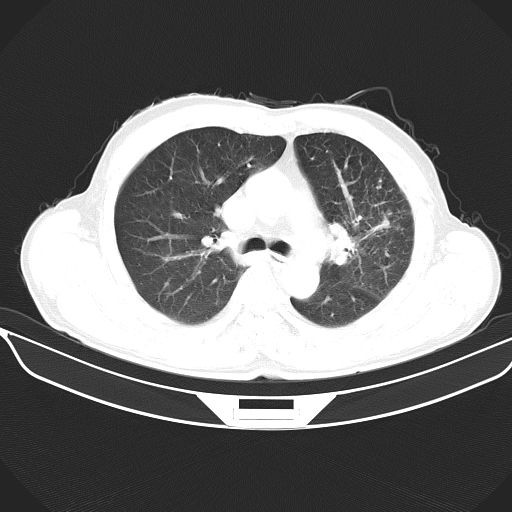
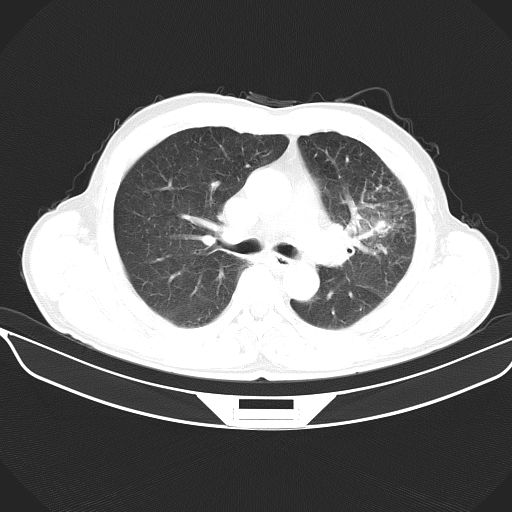
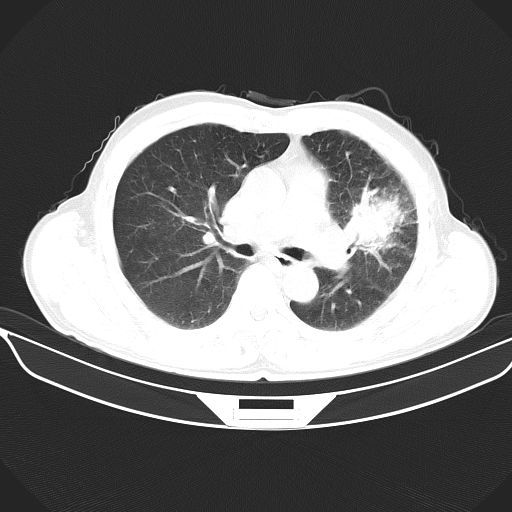
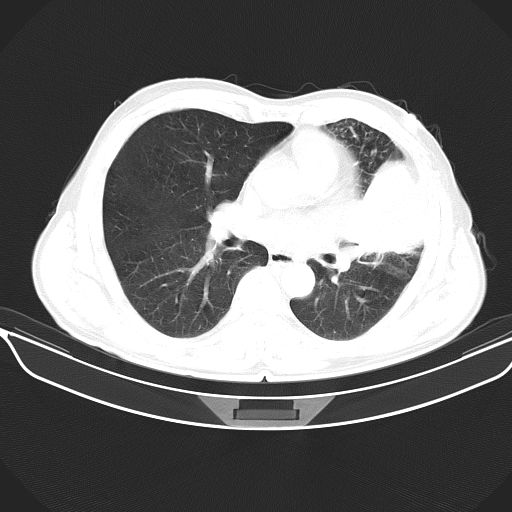
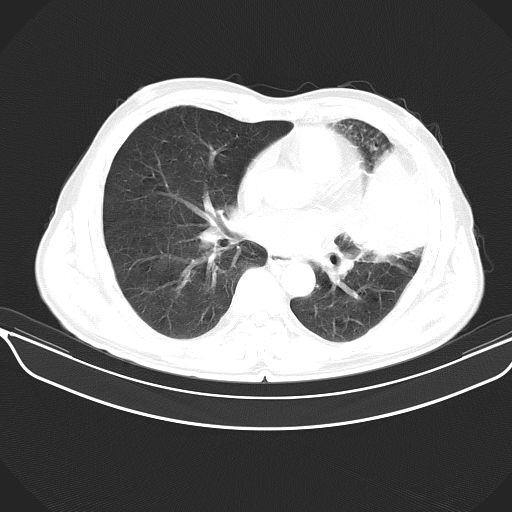
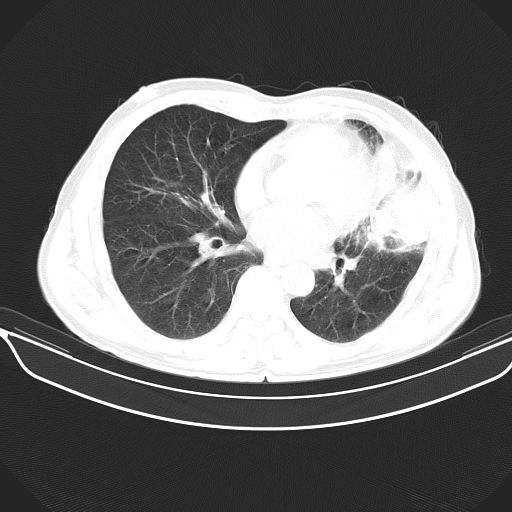
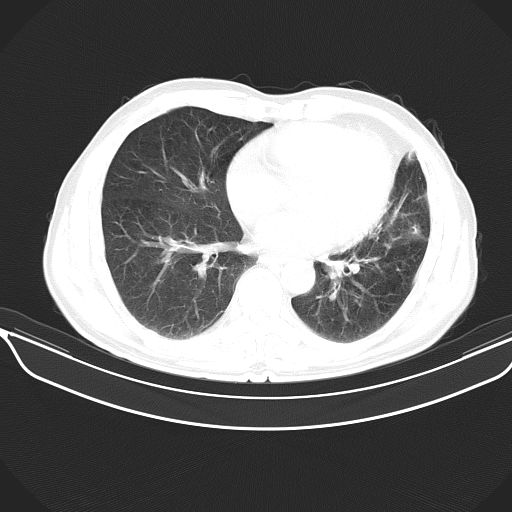
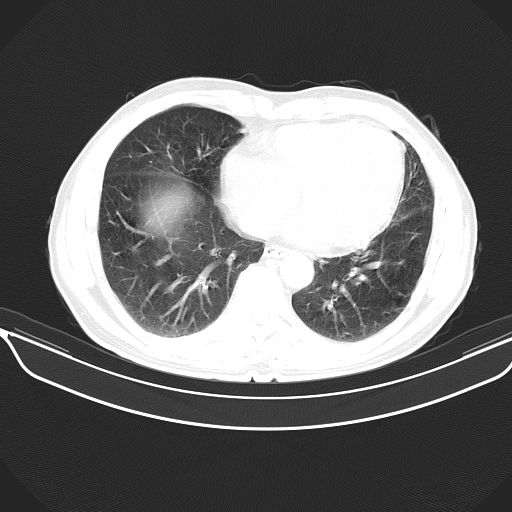
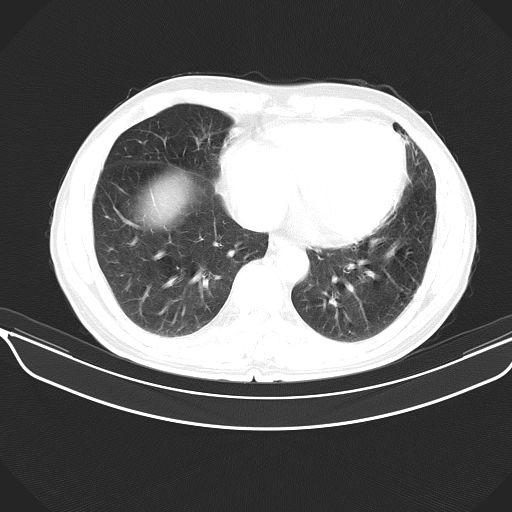
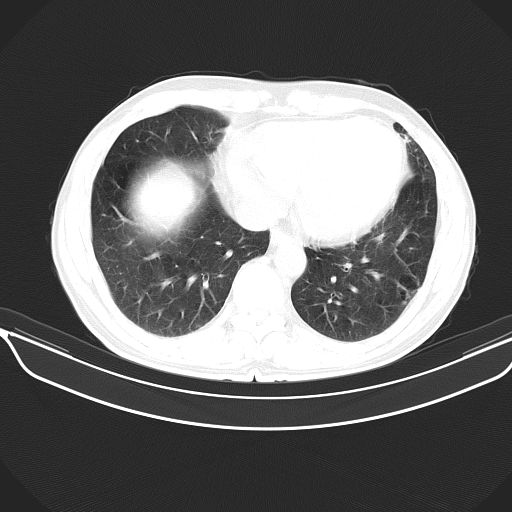

以下是引用心路寻觅在2010-3-1 10:23:00的发言:[br]1、考虑左肺上叶周围型肺癌[br]2、右上肺陈旧性病灶。[br][br][本贴已被 心路寻觅 于 2010-3-1 10:40:18 修改过]
以下是引用shuiyuan在2010-3-1 10:45:00的发言:[br]考虑左肺上叶中心型肺癌伴阻塞型炎症,邻近胸膜受侵。
以下是引用心路寻觅在2010-3-1 10:23:00的发言:[br]1、考虑左肺上叶周围型肺癌[br]2、右上肺陈旧性病灶。[br][br][本贴已被 心路寻觅 于 2010-3-1 10:40:18 修改过]
| 欢迎光临 医影在线 (http://bbs.radida.com/bbs/) | Powered by Discuz! X3.2 |